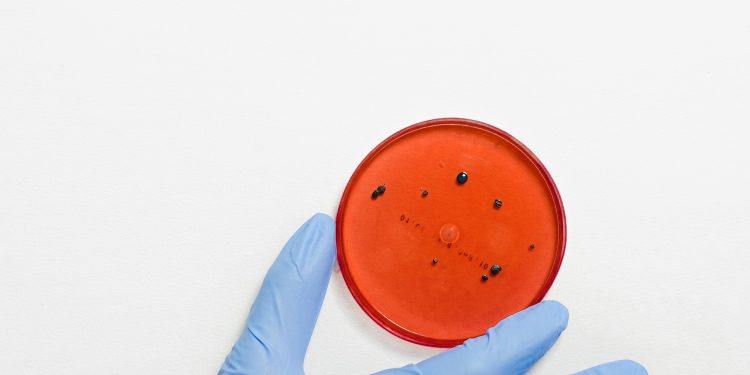

L'antibioticoresistenza è diventata una minaccia sempre più pressante per la salute pubblica in tutto il mondo. L'onorevole Malavasi del Partito Democratico ha sottolineato l'importanza di affrontare questa sfida con urgenza, definendola "una pandemia silente" che richiede un'azione coordinata e immediata.
L'antibioticoresistenza si verifica quando i batteri mutano e diventano in grado di resistere agli effetti degli antibiotici, rendendo le infezioni sempre più difficili da trattare e aumentando il rischio di complicazioni gravi e persino morte. Questo fenomeno è alimentato da un uso eccessivo e non appropriato di antibiotici in ambito medico, veterinario e agricolo.
Affrontare l'antibioticoresistenza richiede un approccio globale e interdisciplinare. È necessario un impegno congiunto da parte di governi, istituzioni sanitarie, industria farmaceutica, professionisti sanitari e pubblico in generale per ridurre l'uso e l'abuso di antibiotici, promuovere pratiche di prescrizione responsabili, migliorare l'igiene e la prevenzione delle infezioni e investire nella ricerca di nuovi antibiotici e alternative terapeutiche.
Una delle proposte dell'onorevole Malavasi è la creazione di una "cabina di regia" dedicata al contrasto dell'antibioticoresistenza. Questo organismo avrebbe il compito di coordinare le azioni e le politiche a livello nazionale e internazionale, monitorare i dati sull'antibioticoresistenza, promuovere la formazione e l'informazione sulla corretta gestione degli antibiotici e favorire la collaborazione tra i diversi attori coinvolti.
Inoltre, è fondamentale sensibilizzare l'opinione pubblica sull'importanza di combattere l'antibioticoresistenza e promuovere comportamenti responsabili nell'uso degli antibiotici. È importante che i pazienti comprendano che gli antibiotici devono essere usati solo quando necessario, seguendo sempre le indicazioni del medico e completando il ciclo di trattamento prescritto.
Per affrontare efficacemente l'antibioticoresistenza, è essenziale anche investire nella ricerca e nello sviluppo di nuovi antibiotici e terapie alternative. Negli ultimi decenni, il tasso di scoperta di nuovi antibiotici si è notevolmente ridotto, mentre il problema dell'antibioticoresistenza continua a crescere. È quindi urgente incentivare la ricerca scientifica in questo settore e sostenere l'innovazione per trovare soluzioni efficaci a lungo termine.
In conclusione, l'antibioticoresistenza rappresenta una minaccia globale per la salute pubblica che richiede un'immediata azione coordinata a livello mondiale. È responsabilità di tutti contribuire a contrastare questo fenomeno e proteggere l'efficacia degli antibiotici per le generazioni future. La proposta di creare una cabina di regia per coordinare le iniziative contro l'antibioticoresistenza è un passo nella giusta direzione, ma è necessario un impegno concreto e continuo da parte di tutti gli attori coinvolti per affrontare con successo questa sfida.